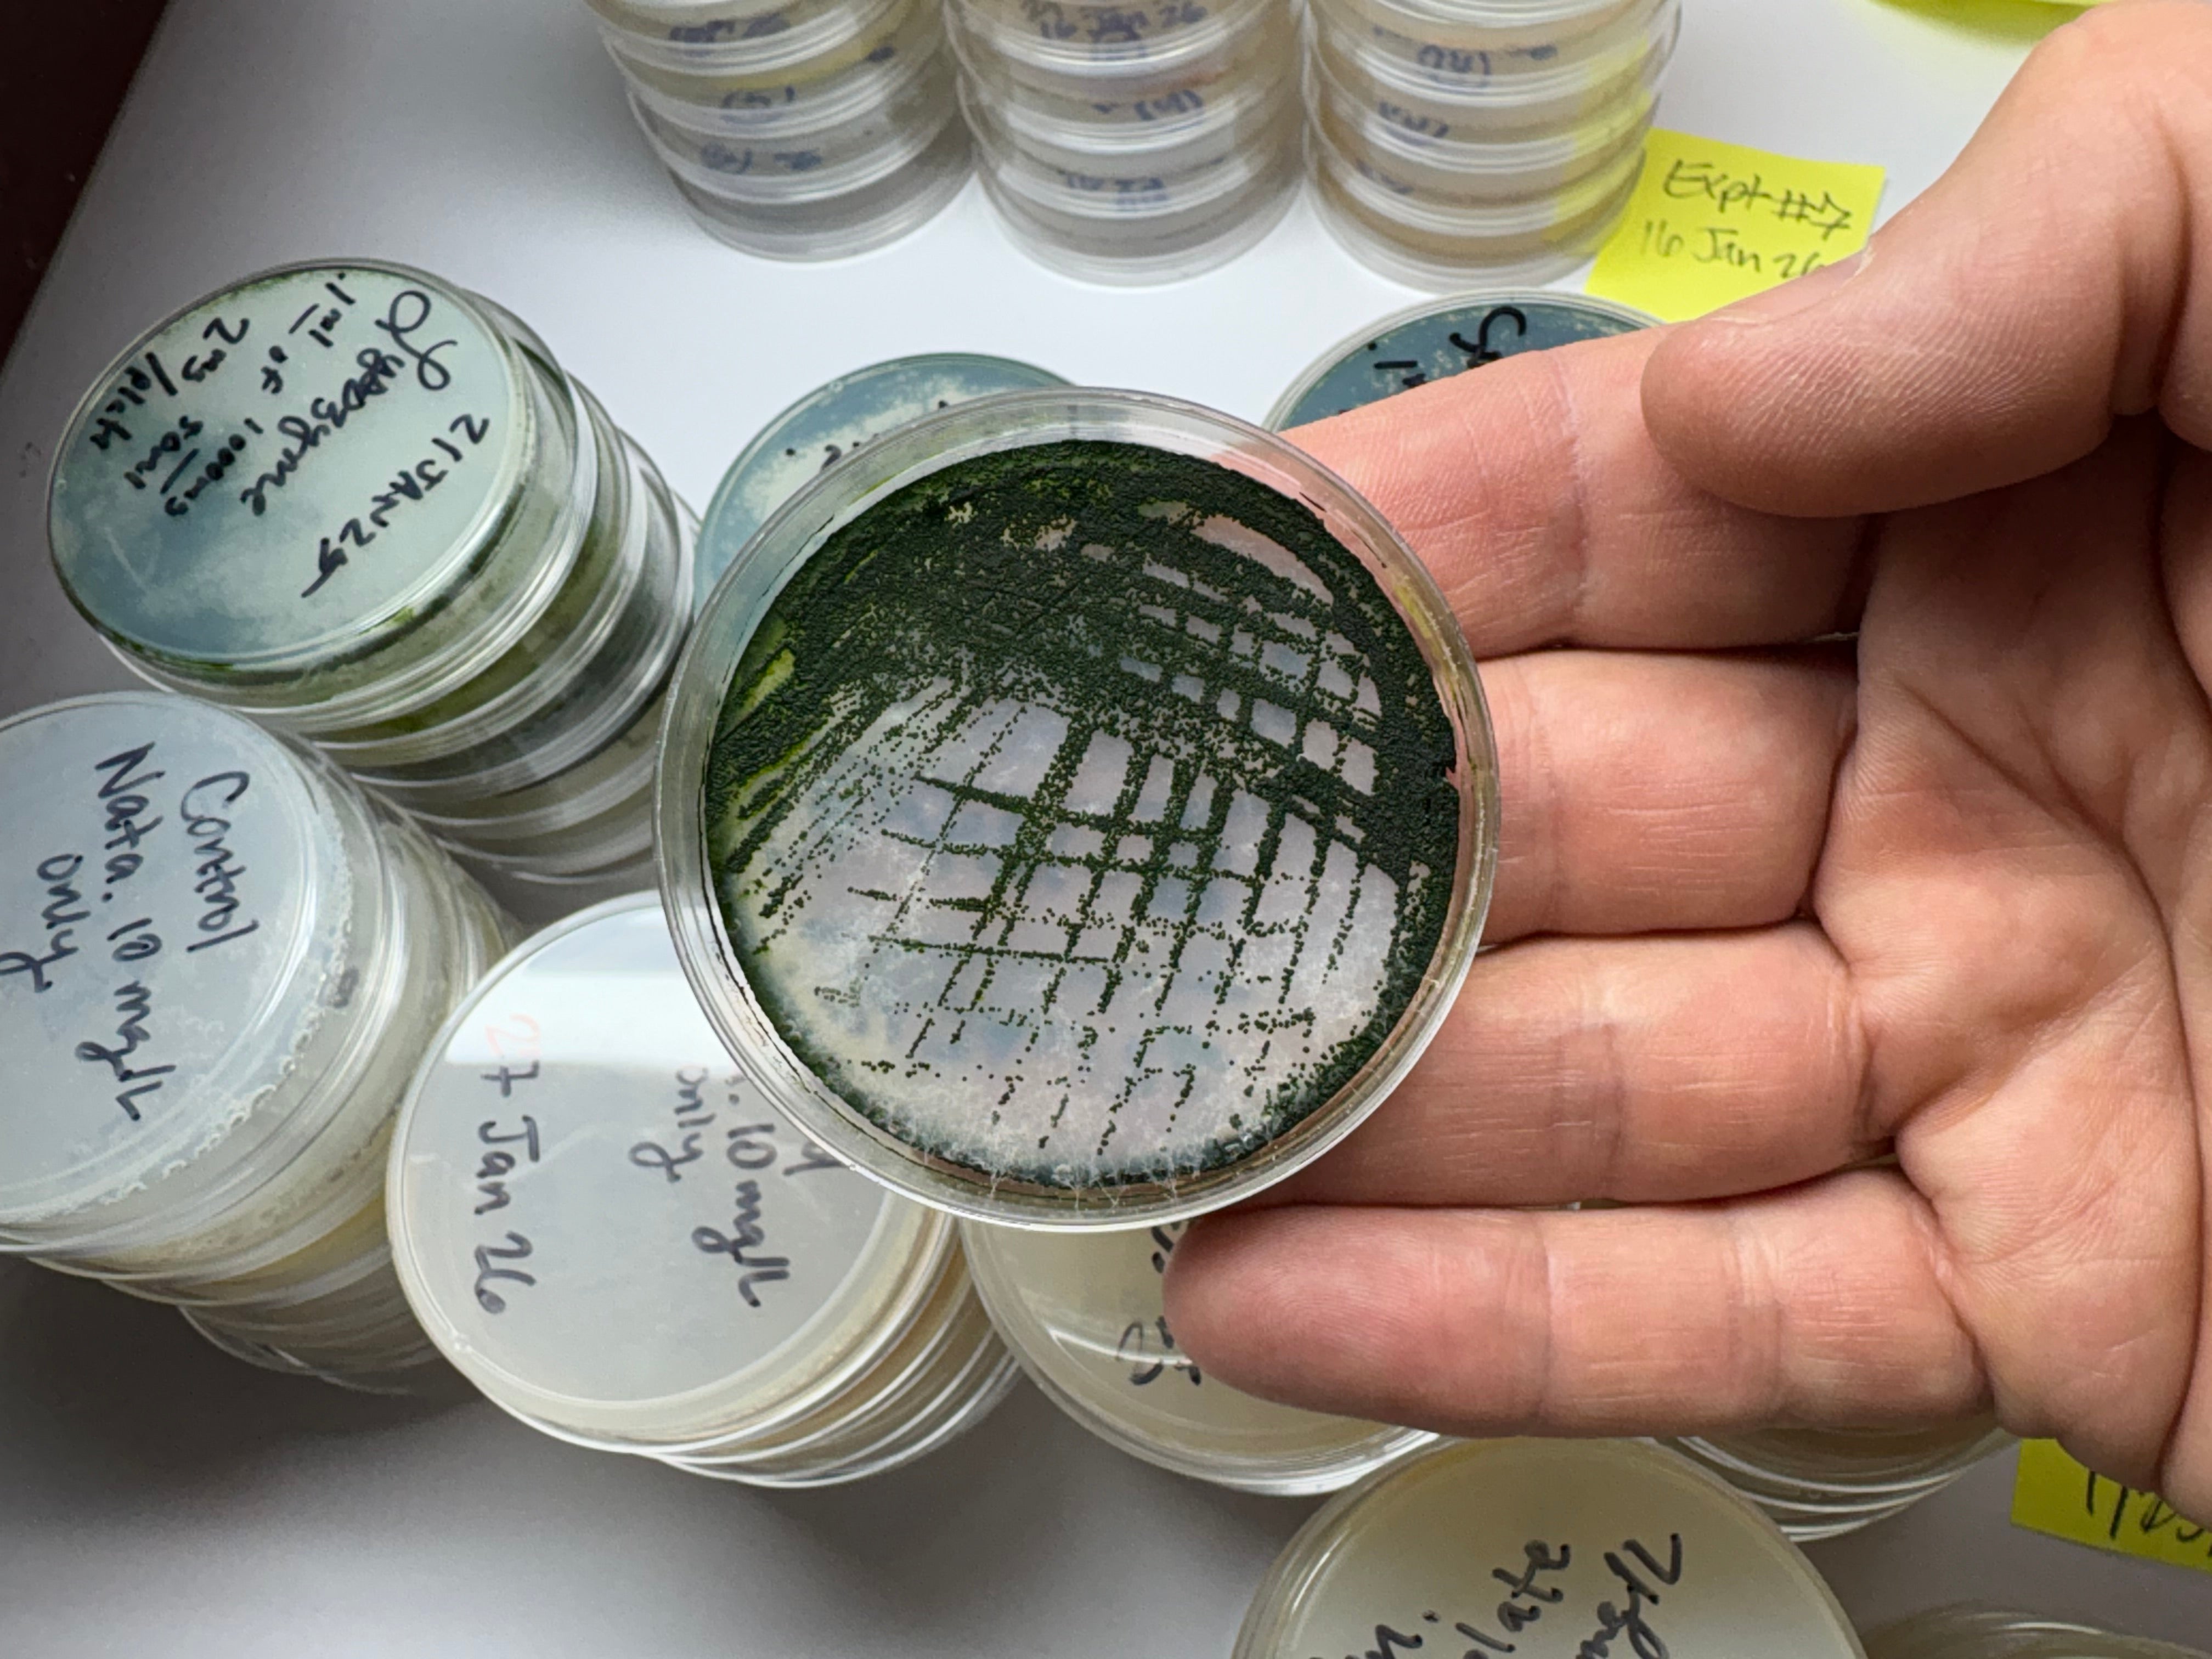

Our Mission:
Algae is responsible for half of the world’s photosynthesis. Our mission at ARS is to train the next generation of scientists and engineers to wield algae as a tool to reverse climate change.




Brainy Briny Fake Fluorescent Food: Microplastic zooplankton bioaccumulation using brine shrimp
$ 29.95
Algae Beads
Vendor:Algae Research Supply
Algae Beads: Make Your Own FULL KIT
$ 119.95
Vendor:Algae Research Supply
Algae Research Supply: Algae Beads
Sale priceFrom $ 4.95Regular price
$ 36.00
Vendor:Algae Research Supply
Concentrated Chlorella sp. for Algae Beads
From $ 23.95
Latest Stories
- by Matthew Huber
Algae Bloom 1/3 the size of Florida Found in Australia
In March 2025, South Australia's southern coastline began experiencing a devastating ecological event: a massive bloom of the toxic algae Karenia mikimotoi. This harmful algal bloom (HAB) has since expanded to cover approximately 4,500 square kilometers, an area roughly equivalent...
- by Matthew Huber
In the transition to sustainable materials, few companies are bridging innovation and scalability as effectively as Noriware, a Swiss-based startup developing biodegradable packaging derived from red algae. At the core of Noriware’s technology is a biopolymer sourced from red algae,...
- by Matthew Huber
Reef aquariums thrive on balance, and that balance starts at the very base of the food web. “Micro Marine Maintenance” is a curated, live community of miniature(mostly smaller than the eye can see) organisms, designed to reinforce your tank’s foundational...